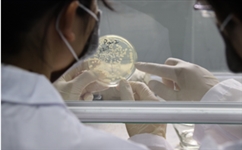
生化除磷处理需要注意些什么

生化除磷工艺是将溶解磷转移到活性污泥生物细胞中,然后通过排泥从系统中排出。但微生物生长通常受环境影响,进而影响脱氮除磷效果。在污水除磷工艺中,主要是利用聚磷菌的新陈代谢完成除磷目的。除了生化工艺中通常需要注意的温度、Ph值、水质水量变化外。
除磷菌属于反硝化菌,在污水运营管理中还需要注意以下内容
1.厌氧段容积一般按0.5-2H的水力停留时间确定。如水中易于生化降解的有机物含量较高时,应当适当减少水力停留时间,保证好氧段进水的BOD5含量。
2.当出现超系统负荷时,可投加化学除磷剂或通过过滤处理,去除生化出水超标总磷。也可通过预处理减少生化系统负荷。
3.有机磷污泥处理建议采用气浮浓缩、机械浓缩、带式重力浓缩等不产生厌氧状态的浓缩方法进行处理,避免剩余污泥在重力浓缩下处理厌氧状态 ,污泥中的磷重新释放出来。如条件限制只能选择重力浓缩时,则须在工艺流程中增设化学沉淀设施去除浓缩液中所含的磷。
4.在生化脱氮除磷工艺中,泥龄过长则会影响除磷效果,而过短则会影响脱氮效果,在生化除磷中,一般建议B0D5/TP小于20时,泥龄控制得越短越好。
相关内容:磷超标用化学除磷剂好还是生化除磷好